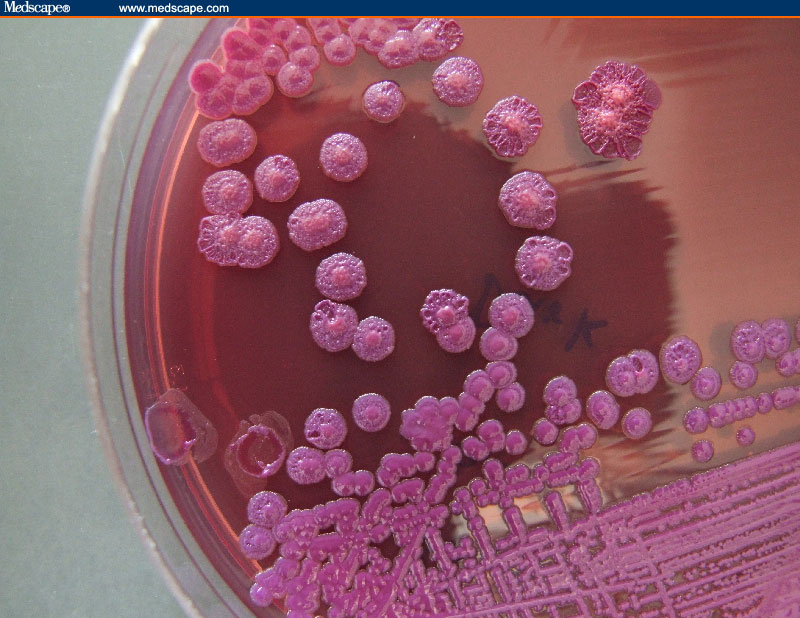

Allarme melioidosi: India, focolaio di un batterio mortale
INDIA - Negli ultimi giorni la notizia di un nuovo batterio particolarmente virulento, ma già conosciuto negli ambienti di ricerca, sta rimbalzando sulle riviste specializzate. La melioidosi, una malattia altamente contagiosa, è ampiamente diffusa in India, secondo un nuovo rapporto dei ricercatori dell'Università di Oxford. Se non curata in tempo può portare alla morte entro due giorni dal contagio. Ma la diagnosi della melioidosi è particolarmente difficile.
Il rapporto, pubblicato anche dalla rivista Nature Microbiology, ha classificato la situazione attuale dell’India, riferita al batterio in questione, come "endemica ma ancora sottostimata", a misura della sua pervasività.
La maggior parte dei casi si registra durante le stagioni delle piogge, quando è maggiore la probabilità di venire a contatto con acque stagnanti.
"Circa il 44 per cento dei casi totali (165.000 ogni anno) a livello mondiale provengono dai paesi dell'Asia meridionale", afferma David Dance dell'Università di Oxford lo scorso novembre durante una conferenza in India. Ma è diffusa anche nei paesi del Sud-est asiatico. "Stimiamo che in tutto il mondo vi siano 165mila casi l'anno di melioidosi, da cui 89mila mortali. Le nostre stime suggeriscono che melioidosi sia gravemente sottovalutata nei 45 paesi dove è conosciuta e che molto probabilmente lo è in altri 34 paesi potenzialmente assoggettabili alla diffusione della malattia", continua il rapporto di Oxford.
Burkholderia pseudomallei è il nome del batterio che provoca melioidosi e si diffonde in acqua e nel terreno. Anche l’Australia settentrionale ne è colpita. I sintomi della malattia comprendono febbre, convulsioni e disturbi respiratori.
In India, ad essere imputati sono i cantieri edili, negli ultimi anni particolarmente diffusi, in quanto i lavoratori maneggiano terra e sabbia. Questo avrebbe portato a una diffusione della malattia su più larga scala. Oltre all'acqua, dunque, i batteri possono essere trasportati attraverso la polvere o il movimento terra.
"Un paziente soggetto a Melioidosi presenta febbre alta, tosse, brividi, infiammazione degli organi interni, dolore alla prostata e alle articolazioni, e un improvviso
accompagnato da un aumento della temperatura, spesso con abbondante sudorazione”, ha detto al quotidiano Mid-day Chiranjay Mukhopadhyay, docente presso il dipartimento di microbiologia al Kasturba Medical College di Manipal, nello stato del Karnataka.
Se la melioidosi si diffonde dalla pelle attraverso il sangue può diventare cronica, colpendo il cuore, cervello, fegato, reni, le articolazioni e gli occhi.
La diagnosi di melioidosi è fatta principalmente con una valutazione al microscopio di un campione di sangue o urine. Tutto sta nel prenderla per tempo. Ma il batterio è velocissimo nella sua trasmissibilità. Non esiste, ad oggi, un vaccino autorizzato. "Una volta contratta la malattia, è difficile da curare", ha affermato Dance. I pazienti diabetici e con patologie renali croniche hanno maggiori probabilità di contrarre la melioidosi.
All rights reserved - © copyright - ph. Silvia Osnago
clicca e scopri come sostenerci







